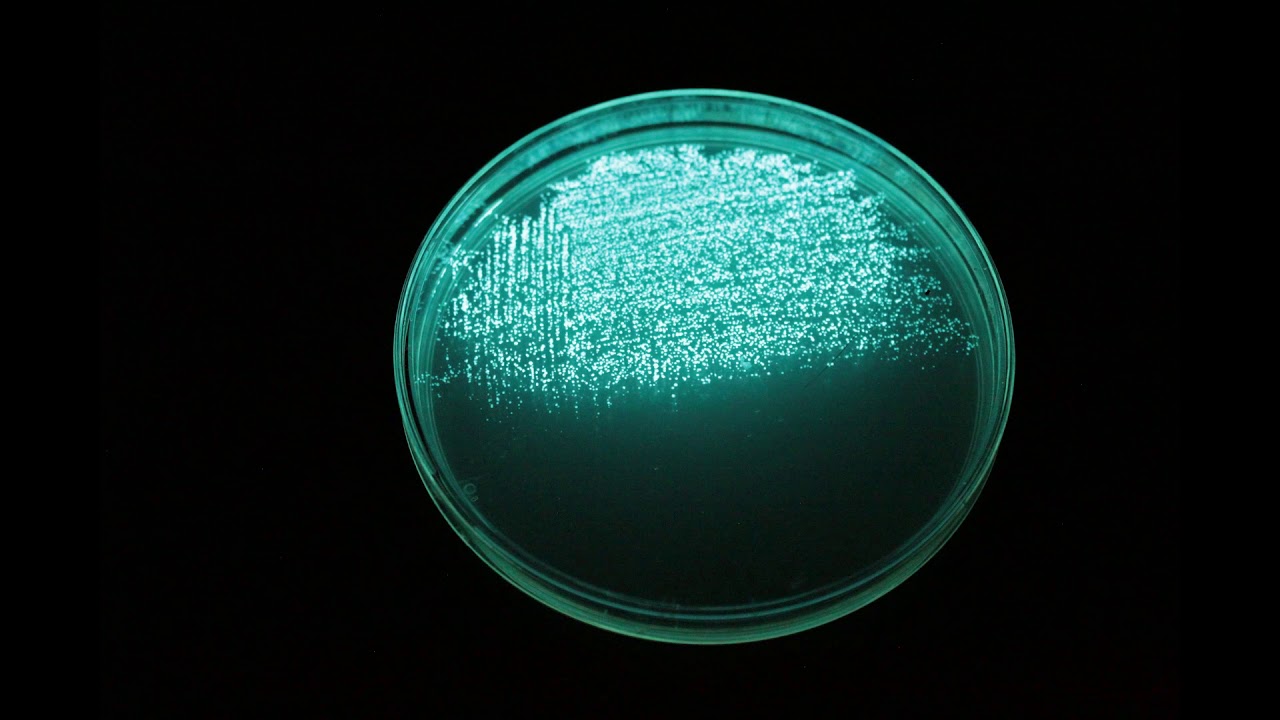
Timelapse - Aliivibrio fischeri

Видео с ютуба Fischeri
![Fischer's Lovebird [Agapornis Fischeri]](https://imager.clipsaver.ru/t2_tc3LG7m4/max.jpg)
Fischer's Lovebird [Agapornis Fischeri]

Tell it to your Mother about a microbe: Aliivibrio fischeri

Vibrio fischeri timelapse

Fischer's Lovebird (Agapornis fischeri)

Xamk EnviTox – 5/6 Introduction to the Aliivibrio fischeri toxicity test

Agapornis fischeri hodowla

The Wild & Colorful World of Fischer's Lovebird (Agapornis Fischeri)

Fischeri Lovebirds Aviary visits in UAE 2024- Part 8(RK Birds AVIARY-Sharjah)
Timelapse - Aliivibrio fischeri

Agapornis fischeri lovebirds

Quorum Sensing in Vibrio fischeri

Vibrio fischeri The slide show!

Brody - Agaporni Fischeri Decino Verde - Green Decino Fischer's Lovebird

Video Encyclopedia of Parrot Species - #157 Agapornis fischeri

Fischer's Lovebird Agapornis fischeri🐦🕊️ 🦜🎵❤️ #2024 #birds #naturelovers #birdwatching #top #bird

Agapornis fischeri - fészekrakás

Fischeri Chicks 🐣

Agapornis Fischeri : Tori, coins, screw and mouse

Different Color and Mutations of Fischer African Lovebirds (Agapornis fischeri) l African Lovebirds

(Agapornis fischeri) After a week

Nierozłączki Fischera (Agapornis fischeri)